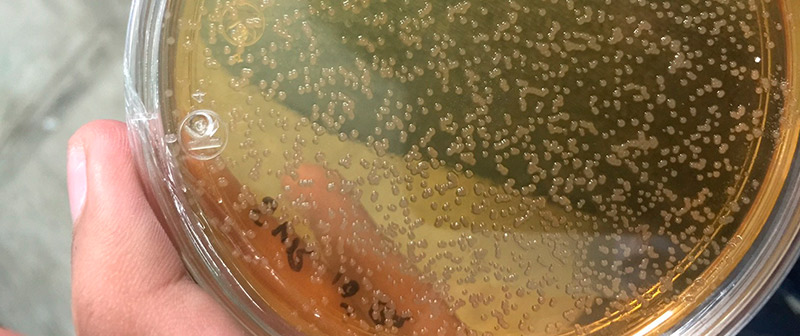
Bacterias devoradoras de petróleo

Se trata de la producción de consorcios microbianos a partir del aceite extraído de semillas de la región para la degradación de hidrocarburos. El proyecto es parte del trabajo de tesis de Sergio Valdivia Rivera, estudiante de la maestría en ciencias en alimentos y biotecnología del ITSTB, bajo la dirección del doctor Manuel Alejandro Lizardi Jiménez, investigador comisionado en el ITSTB.
La sustentabilidad y el aprovechamiento de recursos no explotados son temas preponderantes en las líneas de investigación del Instituto Tecnológico Superior de Tierra Blanca (ITSTB) —el cual forma parte del Tecnológico Nacional de México (Tecnm)—, como es el caso de su reciente proyecto de investigación, orientado al aprovechamiento de aceites orgánicos residuales para la producción de consorcios microbianos que degraden hidrocarburos y la evaluación de la contaminación de mantos acuíferos causada por hidrocarburos.
Se trata de la producción de consorcios microbianos a partir del aceite extraído de semillas de la región para la degradación de hidrocarburos. El proyecto es parte del trabajo de tesis de Sergio Valdivia Rivera, estudiante de la maestría en ciencias en alimentos y biotecnología del ITSTB, bajo la dirección del doctor Manuel Alejandro Lizardi Jiménez, investigador comisionado en el ITSTB.
El propósito de esta línea de investigación es la producción de consorcios microbianos degradadores de hidrocarburos, diseñados para cada condición de contaminación. En entrevista con la Agencia Informativa Conacyt, Manuel Lizardi, especialista en biotecnología, explicó que el desarrollo intensivo de la industria petrolera provoca la contaminación del entorno natural debido a los derivados del petróleo que tienen contacto con cuerpos de agua, por lo que es pertinente incluir un diagnóstico sobre este tipo de contaminación.
La contaminación por hidrocarburos
“Es necesario conocer el alcance y magnitud del problema para así poder dimensionar la alternativa biotecnológica de remediación, como el uso de biorreactores para la producción de consorcios microbianos degradadores de hidrocarburos diseñados ex profeso para cada condición de contaminación”, precisó Manuel Lizardi.
Debido a la actividad petroquímica presente en la región, existe evidencia de hidrocarburos en el agua que pueden ocasionar perturbaciones en los ecosistemas acuáticos por compuestos químicos que son capaces de dañar plantas y animales.
Una propuesta sustentable

El proyecto denominado Evaluación de aceites de residuos industriales de la Cuenca del Papaloapan, como fuente de carbono para la producción de consorcios microbianos hidrocarbonoclastas, elaborado por el estudiante de maestría en ciencias en alimentos y biotecnología, con la dirección del doctor Manuel Lizardi, propone el uso de aceites extraídos de las semillas de mango y papaya para la propagación de consorcios microbianos que auxilien en la degradación de hidrocarburos.
“Una de las ideas principales del proyecto es dotar de un valor agregado los residuos agrícolas que se generan en la zona. En la Cuenca del Papaloapan existe multitud de cultivos de los cuales se generan mermas y residuos que, además, tienen potencial para aprovecharse”, detalló Sergio Valdivia Rivera.
Los aceites extraídos de las semillas de mango y papaya como fuente de carbono ayudan al crecimiento y proliferación de los consorcios microbianos destinados a la degradación de hidrocarburos. Para este proyecto, los especialistas conformaron consorcios con los microrganismos Xanthomonas, Acinetobacter bouvetii, Shewanella y Defluvibacter lusatiensis.
Respecto a los consorcios microbianos, el doctor Manuel Lizardi, director del proyecto, aseguró que son capaces de degradar hidrocarburos alifáticos, como decano y hexadecano, y aromáticos cancerígenos, como benceno, fenantreno y naftaleno (70 g L-1) en un tiempo aproximado de 14 días, tanto por contacto directo como de manera mediada por un biosurfactante.
Los consorcios microbianos habitualmente se encuentran en zonas contaminadas por hidrocarburos, por lo que el primer paso es aislarlos del ambiente y, posteriormente, alimentarlos con fuentes de carbono que les permiten multiplicarse.
El proceso para llegar a los consorcios microbianos listos para alimentarse de hidrocarburos consta de tres pasos: seleccionar las cepas microbianas hidrocarbonoclastas, cultivar un biorreactor semilla con agua de mar como medio de cultivo y, finalmente, cultivar los consorcios microbianos en biorreactores, con control de oxígeno, pH y temperatura, usando el aceite de semilla de mango y el aceite de semilla de papaya como fuentes de carbono.
Devoradores de hidrocarburos
La beta oxidación es una de las vías metabólicas de las que se valen los consorcios microbianos para consumir los hidrocarburos; basta con que el microorganismo entre en contacto con el hidrocarburo contaminante para que inicie el proceso de reducción.

“Los microorganismos se valen de distintas moléculas, como el dióxido de carbono, el oxígeno o incluso algunos iones metálicos como el hierro para ir degradando el hidrocarburo a formas más sencillas y menos contaminantes”, indicó Sergio Valdivia.
De esta manera, los especialistas del ITSTB aprovechan las capacidades metabólicas de los microorganismos para eliminar los hidrocarburos contaminantes, y usan residuos agrícolas como materia prima para las fuentes de carbono, lo que, en conjunto, es una alternativa de bajo costo.
Sergio Valdivia agregó que, en este sentido, los residuos agrícolas son muy llamativos, pues como materia prima tienen un costo casi nulo. Además, en el país los porcentajes de mermas y residuos de alimentos son lo suficientemente altos para satisfacer la demanda de microorganismos biorremediadores.
Evaluación de zonas contaminadas

El doctor Manuel Lizardi Jiménez, quien es parte de Cátedras Conacyt, actualmente dirige un proyecto enfocado en la evaluación de ríos contaminados por hidrocarburos en la zona sur del país. Para hacer posible esta evaluación, contó con el financiamiento del Fondo de Infraestructura de Conacyt, que le permitió adquirir el equipamiento necesario para iniciar la evaluación por contaminación de hidrocarburos en cuerpos de agua del estado de Veracruz y biorreactores para la producción de consorcios microbianos degradadores de hidrocarburos.
Los cuerpos de agua contemplados para la evaluación son: río Hondo, río Coatzacoalcos, laguna Real, río Mazinga, laguna de Tamiahua, río Jamapa, laguna de Catemaco, río Filobobos, río Tecolutla y río Pantepec.
La identificación de hidrocarburos se realizará mediante cromatografía de gases, que consiste en un análisis químico en donde la muestra se evapora y permite la separación de compuestos orgánicos e inorgánicos, estables y volátiles.
“En otras palabras, la cromatografía de gases permite detectar la presencia de hidrocarburos en el agua a concentraciones tan pequeñas como un mililitro de hidrocarburo en mil litros de agua. Cuando la muestra es inyectada al cromatógrafo, esta pasa por una columna que va reteniendo los compuestos que la forman, con base en sus pesos moleculares, de tal forma que cuando salen de la columna lo hacen de forma ya separada, y en el extremo de salida hay un detector que permite identificar qué compuesto es y en qué concentración se encuentra”, finalizó el doctor Manuel Lizardi.